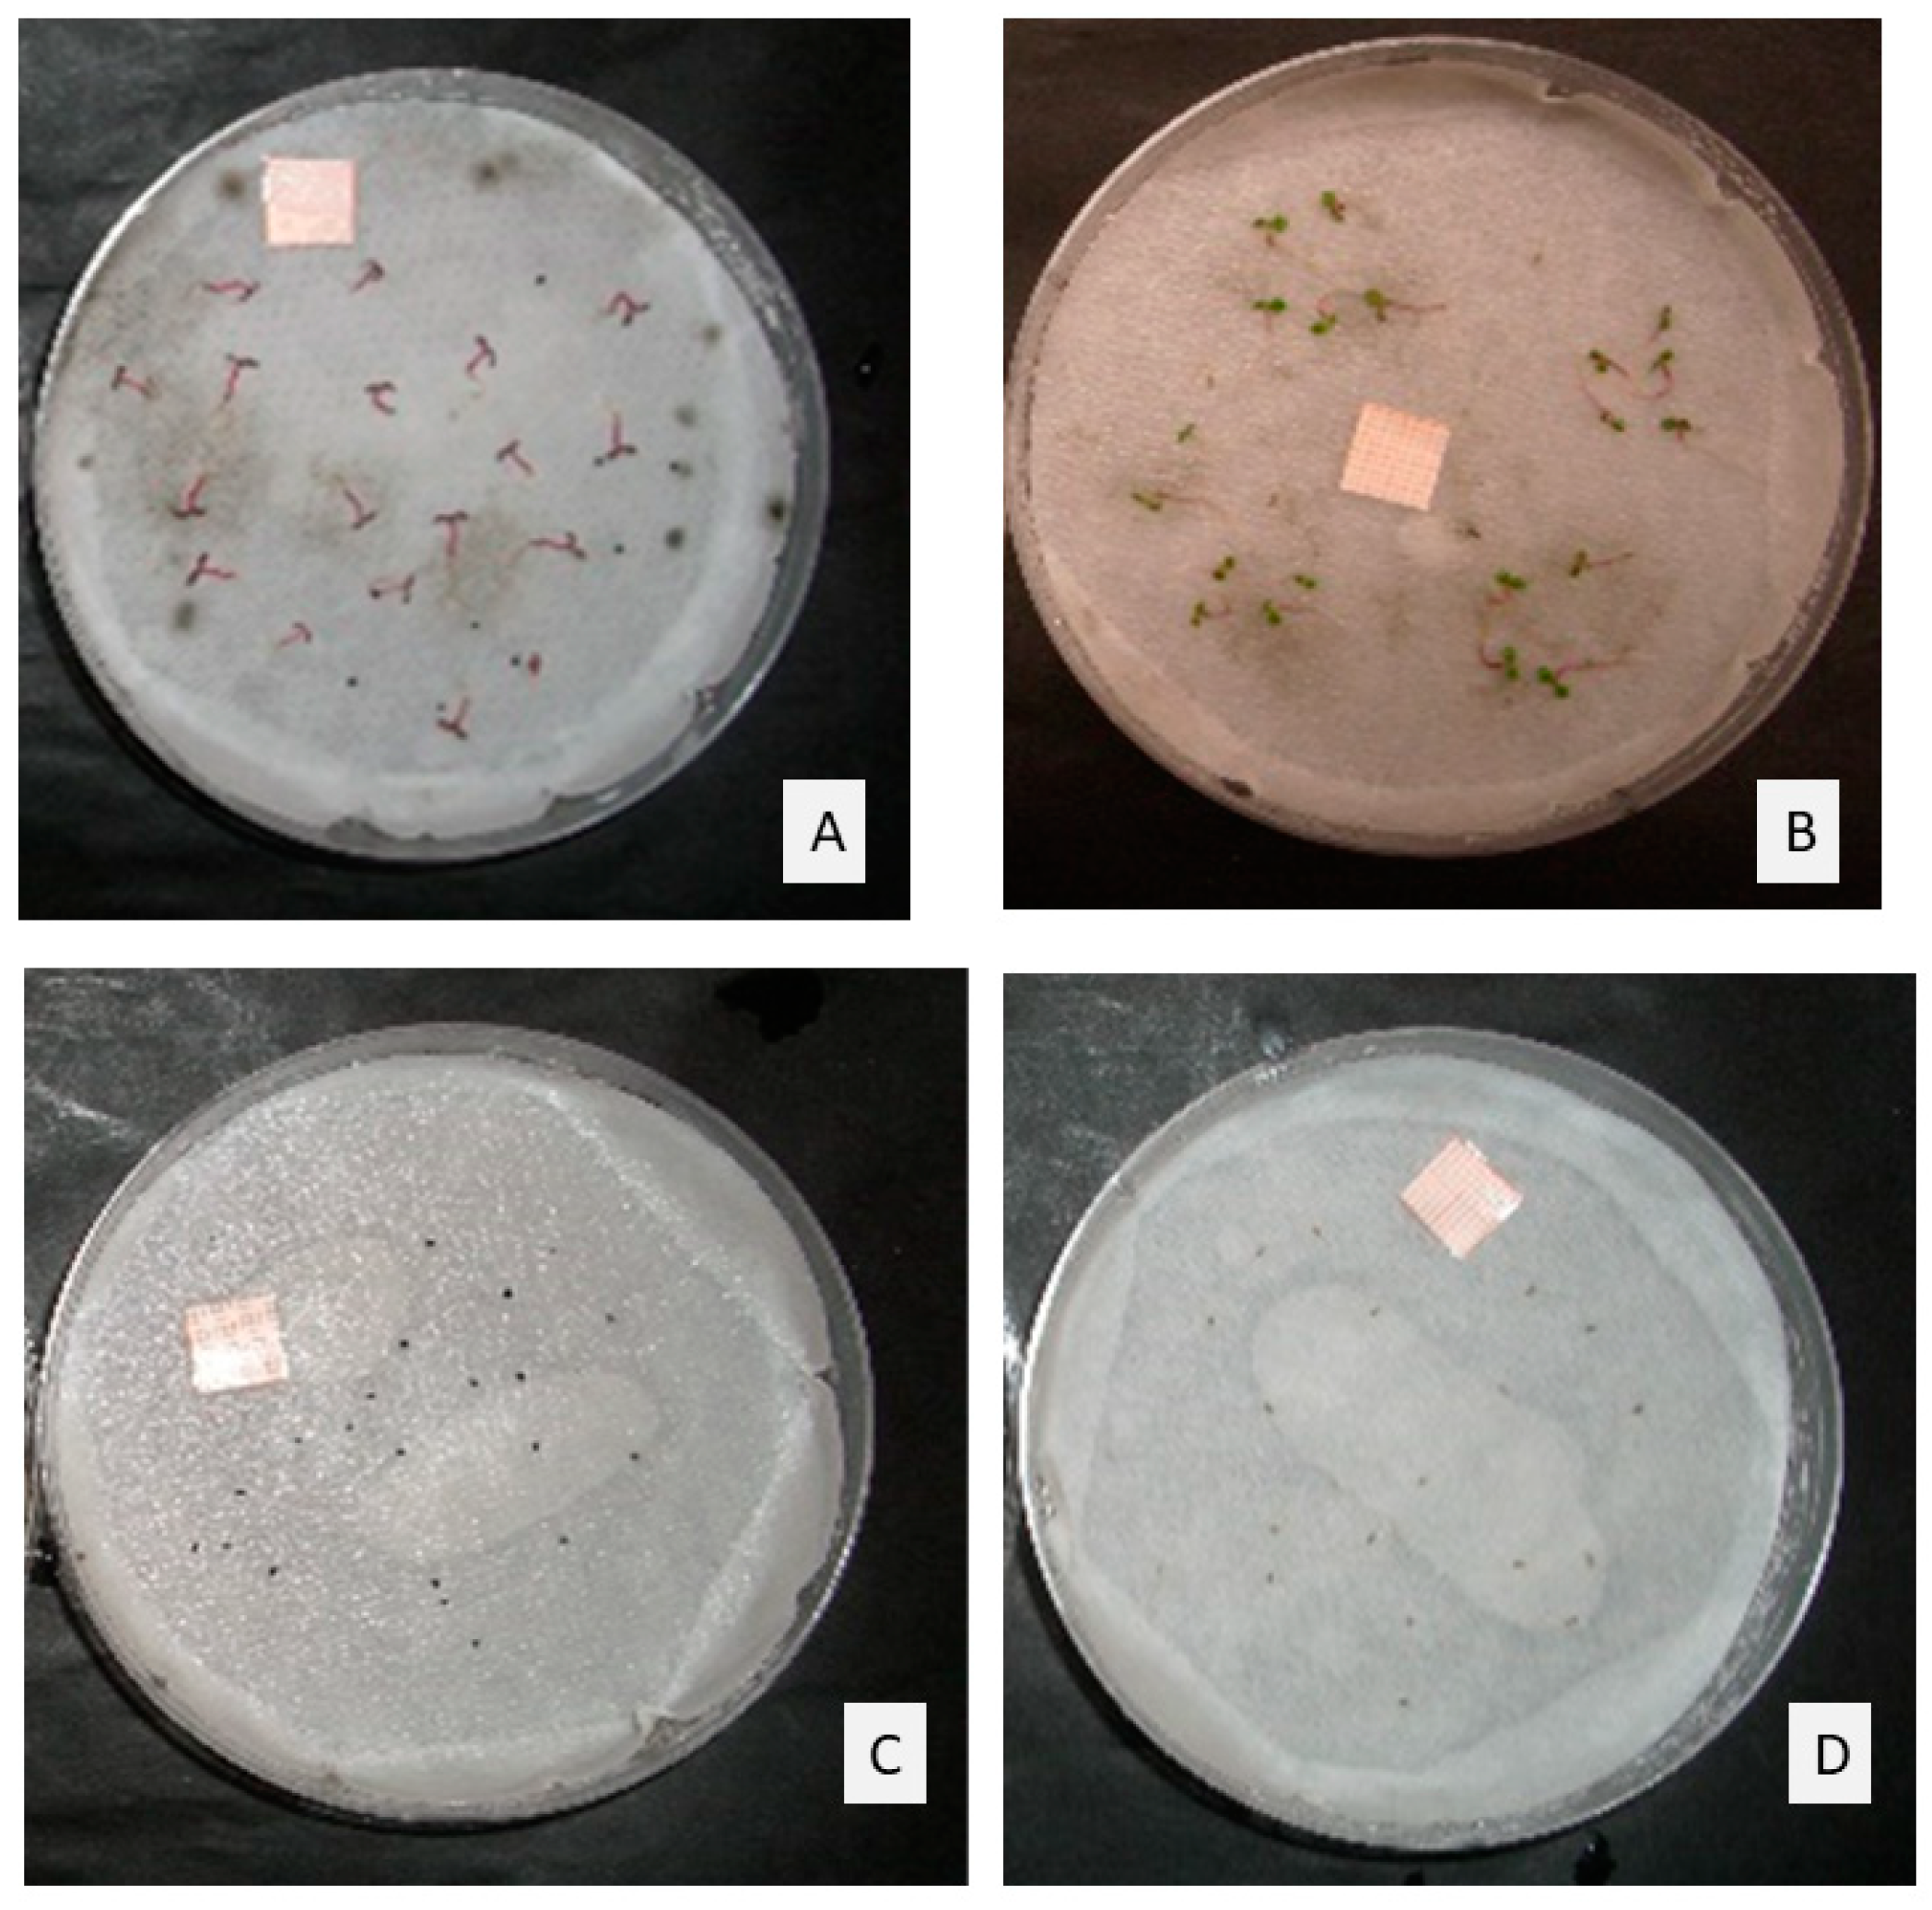
Molecules 25 02832 g002

Author Contributions
Conceptualization, M.V., M.A.B., A.S., S.A., A.C., M.B., and A.M.S.-M.; methodology, M.V., M.A.B., A.M.S.-M., A.S., A.C., S.G.-P., P.C., L.C.-F., L.R.-M.; validation, M.V., M.A.B., A.M.S.-M., A.C., M.B., and A.S.; formal analysis, M.V., A.M.S.-M.; investigation: all authors; resources, M.V., M.B., A.M.S.-M., M.A.B., A.S., A.C., and S.A.; data curation: all authors.; writing—original draft preparation, M.V., N.T.-P., M.M., A.J., A.M.S.-M.; writing—review and editing, M.V., N.T.-P., A.M.S.-M.; visualization, M.V., A.M.S.-M.; supervision, M.V., A.M.S.-M., M.A.B., A.C., M.B.; project administration, M.V., A.M.S.-M.; funding acquisition, M.V., A.M.S.-M. All authors have read and agreed to the published version of the manuscript.
Figure 1.
Seedling length (mm) (mean ± SE) in Portulaca oleracea control or treated with TC1 (A) and TC2 (B). Different letters at the end of the growth curves indicate significant differences among doses (p < 0.05) using Fisher’s least significant difference (LSD) test.
Figure 1.
Seedling length (mm) (mean ± SE) in Portulaca oleracea control or treated with TC1 (A) and TC2 (B). Different letters at the end of the growth curves indicate significant differences among doses (p < 0.05) using Fisher’s least significant difference (LSD) test.
Figure 2.
Seeds in control plates of (A) Portulaca oleracea, and (B) Erigeron canadensis, and seeds treated with the maximum doses of TC1 (1 µL/mL) of (C) P. oleracea, and (D) E. canadensis, after 14-days incubation.
Figure 2.
Seeds in control plates of (A) Portulaca oleracea, and (B) Erigeron canadensis, and seeds treated with the maximum doses of TC1 (1 µL/mL) of (C) P. oleracea, and (D) E. canadensis, after 14-days incubation.
Figure 3.
Phytotoxic effects of Thymbra capitata EO (TC3) on Solanum nigrum (A) and Setaria verticillata (B) seedling length (mm) (mean ± SE), measured for 14 days. Different letters at the end of the growth curves indicate significant differences among doses (p < 0.05) using Fisher’s least significant difference (LSD) test.
Figure 3.
Phytotoxic effects of Thymbra capitata EO (TC3) on Solanum nigrum (A) and Setaria verticillata (B) seedling length (mm) (mean ± SE), measured for 14 days. Different letters at the end of the growth curves indicate significant differences among doses (p < 0.05) using Fisher’s least significant difference (LSD) test.
Figure 4.
Phytotoxic effects of Thymbra capitata EO (TC4) on A. retroflexus (A), P. oleracea (B), A. fatua (C) and E. crus-galli (D) seedling length (mm) (mean ± SE), measured for 14 days. Different letters at the end of the growth curves indicate significant differences among doses (p < 0.05) using Fisher’s least significant difference (LSD) test.
Figure 4.
Phytotoxic effects of Thymbra capitata EO (TC4) on A. retroflexus (A), P. oleracea (B), A. fatua (C) and E. crus-galli (D) seedling length (mm) (mean ± SE), measured for 14 days. Different letters at the end of the growth curves indicate significant differences among doses (p < 0.05) using Fisher’s least significant difference (LSD) test.
Figure 5.
Effect of TC3, injected into the soil, on the number of weeds grown in treated pots.
Figure 5.
Effect of TC3, injected into the soil, on the number of weeds grown in treated pots.
Figure 6.
Effect of TC3, supplied with water, using Tween 20 as emulsifier, on the number of weeds grown in treated pots.
Figure 6.
Effect of TC3, supplied with water, using Tween 20 as emulsifier, on the number of weeds grown in treated pots.
Figure 7.
Effect of TC3, supplied with water, using Fitoil as emulsifier, on the number of weeds grown in treated pots.
Figure 7.
Effect of TC3, supplied with water, using Fitoil as emulsifier, on the number of weeds grown in treated pots.
Figure 8.
Effect of T1 to T6 treatments applied in pre-emergence on the number of plants grown (mean ± standard error) in the trays where they were applied.
Figure 8.
Effect of T1 to T6 treatments applied in pre-emergence on the number of plants grown (mean ± standard error) in the trays where they were applied.
Figure 9.
Effect of T1 to T6 treatments applied in post-emergence on the number of plants grown (mean ± standard error) in the trays where they were applied.
Figure 9.
Effect of T1 to T6 treatments applied in post-emergence on the number of plants grown (mean ± standard error) in the trays where they were applied.
Figure 10.
(A) Scanned images of Arabidopsis thaliana seedlings treated with 0, 200, 300 and 400 μM carvacrol (B) Dose–response curve of radicle length of Arabidopsis thaliana seedlings after 14 d of carvacrol treatment (0, 100, 200, 400, 800, 1200 μM). Points marked with asterisks are significantly different from the control (p ≤ 0.05).
Figure 10.
(A) Scanned images of Arabidopsis thaliana seedlings treated with 0, 200, 300 and 400 μM carvacrol (B) Dose–response curve of radicle length of Arabidopsis thaliana seedlings after 14 d of carvacrol treatment (0, 100, 200, 400, 800, 1200 μM). Points marked with asterisks are significantly different from the control (p ≤ 0.05).
Figure 11.
Apical region and transition zone of A. thaliana roots after 14 days of growth in agar with 0 (A), 100 (B), 200 (C), and 400 (D) μM carvacrol. Images were taken with a magnifier (Nikon SMZ 1500, Melville, NY, USA).
Figure 11.
Apical region and transition zone of A. thaliana roots after 14 days of growth in agar with 0 (A), 100 (B), 200 (C), and 400 (D) μM carvacrol. Images were taken with a magnifier (Nikon SMZ 1500, Melville, NY, USA).
Figure 12.
Greenhouse conditions during the experiment testing TC3 EO application directly injected into the soil or supplied with water, emulsified with Tween 20 or Fitoil.
Figure 12.
Greenhouse conditions during the experiment testing TC3 EO application directly injected into the soil or supplied with water, emulsified with Tween 20 or Fitoil.
Figure 13.
Damage level scale of Avena fatua. 0 Undamaged plant, 1 Plant with slight damage, 2 Plant with severe damage, 3 Critically damaged plant, 4 Dead plant.
Figure 13.
Damage level scale of Avena fatua. 0 Undamaged plant, 1 Plant with slight damage, 2 Plant with severe damage, 3 Critically damaged plant, 4 Dead plant.
Figure 14.
Damage level scale of Echinochloa crus-galli. 0 Undamaged plant, 1 Plant with slight damage, 2 Plant with severe damage, 3 Critically damaged plant, 4 Dead plant.
Figure 14.
Damage level scale of Echinochloa crus-galli. 0 Undamaged plant, 1 Plant with slight damage, 2 Plant with severe damage, 3 Critically damaged plant, 4 Dead plant.
Figure 15.
Damage level scale of Portulaca oleracea. 0 Undamaged plant, 1 Plant with slight damage, 2 Plant with severe damage, 3 Dead plant.
Figure 15.
Damage level scale of Portulaca oleracea. 0 Undamaged plant, 1 Plant with slight damage, 2 Plant with severe damage, 3 Dead plant.
Table 1.
Chemical composition of Thymbra capitata EOs tested. TC1, T. capitata from Enna (Enna province, Sicily) collected at flowering stage, TC2, T. capitata from Riesi (Caltanissetta province, Sicily) collected at vegetative stage. TC3, T. capitata from Carmona (Seville province, Spain) collected at flowering stage. TC4, EO purchased from Bordas, S.A. (Seville province, Spain).
Table 1.
Chemical composition of Thymbra capitata EOs tested. TC1, T. capitata from Enna (Enna province, Sicily) collected at flowering stage, TC2, T. capitata from Riesi (Caltanissetta province, Sicily) collected at vegetative stage. TC3, T. capitata from Carmona (Seville province, Spain) collected at flowering stage. TC4, EO purchased from Bordas, S.A. (Seville province, Spain).
| Component | KI | TC1 | TC2 | TC3 | TC4 |
|---|
| Monoterpene Hydrocarbons | | 10.42 | 18.35 | 17.33 | 22.54 |
| α-Thujene | 931 | - | 0.86 | 2.10 | 0.89 |
| α-Pinene | 939 | 0.48 | 0.65 | 0.71 | 0.74 |
| Camphene | 954 | 0.19 | 0.33 | 0.09 | - |
| β-Pinene | 979 | 0.08 | 0.10 | 0.06 | 0.29 |
| Myrcene | 991 | 1.06 | 1.39 | 2.03 | 1.95 |
| α-Phellandrene | 1006 | 0.05 | 0.01 | 0.27 | 0.16 |
| δ-3-Carene | 1010 | t | t | 0.08 | - |
| α-Terpinene | 1017 | 0.64 | 0.55 | 1.37 | 1.61 |
| p-Cymene | 1026 | 6.78 | 12.07 | 4.57 | 8.93 |
| Limonene | 1030 | 0.17 | 0.38 | 0.23 | 0.20 |
| β-Phellandrene | 1036 | - | - | 0.24 | - |
| trans-β-Ocimene | 1052 | - | - | 0.05 | - |
| γ-Terpinene | 1060 | 0.97 | 2.01 | 5.45 | 7.77 |
| Terpinolene | 1090 | t | t | 0.08 | |
| Oxygenated Monoterpenes | | 78.94 | 68.79 | 79.07 | 73.98 |
| 1,8-Cineole | 1033 | t | - | - | 0.11 |
| cis-Sabinene hydrate | 1079 | 0.38 | 0.33 | 0.19 | - |
| trans-Sabinene hydrate | 1095 | t | t | - | - |
| Linalool | 1100 | 0.40 | 1.26 | 0.93 | 0.77 |
| Borneol | 1179 | t | t | 0.06 | 0.16 |
| Terpinen-4-ol | 1188 | 0.82 | 1.11 | 0.54 | 0.37 |
| Cryptone | 1202 | - | 0.04 | - | - |
| Thymol | 1292 | - | - | 0,22 | 0.27 |
| Carvacrol | 1302 | 77.02 | 65.55 | 77.13 | 72.30 |
| Carvacrol acetate | 1374 | 0.32 | 0.50 | - | - |
| Sesquiterpene Hydrocarbons | | 4.74 | 8.02 | 2.50 | 3.14 |
| β-Caryophyllene | 1419 | 4.42 | 6.99 | 2.50 | 3.14 |
| Aromadendrene | 1442 | - | 0.10 | - | - |
| α-Humulene | 1457 | - | t | - | - |
| allo-Aromadendrene | 1459 | - | 0.04 | - | - |
| Bicyclogermacrene | 1500 | - | 0.21 | - | - |
| β-Bisabolene | 1507 | 0.24 | 0.68 | - | - |
| Ƴ-Cadinene | 1516 | - | t | - | - |
| δ-Cadinene | 1526 | 0.08 | t | - | - |
| Oxygenated Sesquiterpenes | | 1.32 | 2.34 | | 0.14 |
| Spathulenol | 1581 | t | 0.21 | - | - |
| Caryophyllene oxide | 1586 | 1.32 | 2.13 | - | 0.14 |
| Diterpene hydrocarbons | - | 0.11 | - | - | - |
| Abietatriene | 2072 | 0.11 | - | - | - |
| Aromatics | - | 1.77 | - | - | - |
| Eugenol | 1361 | 1.77 | - | - | - |
| Chavibetol acetate | 1520 | t | - | - | - |
| Others | | 0.30 | 0.38 | 0.18 | - |
| 1-Octen-3-ol | 979 | 0.30 | 0.32 | 0.18 | - |
| 3-Octanol | 997 | t | t | t | - |
| 2-Nonanone | 2100 | t | 0.06 | | |
| TOTAL IDENTIFIED (%) | | 97.60 | 97.88 | 99.08 | 99.08 |
Table 2.
Phytotoxic effects of Thymbra capitata EOs obtained from plants at blooming (TC1) and vegetative stage (TC2) and carvacrol, on Portulaca oleracea and Erigeron canadensis seed germination.
Table 2.
Phytotoxic effects of Thymbra capitata EOs obtained from plants at blooming (TC1) and vegetative stage (TC2) and carvacrol, on Portulaca oleracea and Erigeron canadensis seed germination.
| Seed Germination (%) |
|---|
| | Concentration µL/mL | Portulaca oleracea | Conyza canadensis |
|---|
| TC1 | 0 (control) | 87.0 ± 1.2 a | 94.0 ± 2.4 a |
| 0.125 | 46.0 ± 1.4 b | 0.0 ± 0.0 b |
| 0.250 | 7.0 ± 3.7 c | 0.0 ± 0.0 b |
| 0.5 | 0.0 ± 0.0 c | 0.0 ± 0.0 b |
| 1 | 0.0 ± 0.0 c | 0.0 ± 0.0 b |
| TC2 | 0 (control) | 87.0 ± 1.2 a | 94.0 ± 2.4 a |
| 0.125 | 39.0 ± 9.3 b | 0.0 ± 0.0 b |
| 0.250 | 0.0 ± 0.0 c | 0.0 ± 0.0 b |
| 0.5 | 0.0 ± 0.0 c | 0.0 ± 0.0 b |
| 1 | 4.0 ± 4.0 c | 0.0 ± 0.0 b |
| Carvacrol | 0 (control) | 88.8 ± 5.5 a | 95.0 ± 2.2 a |
| 0.125 | 0.0 ± 0.0 b | 0.0 ± 0.0 b |
| 0.250 | 0.0 ± 0.0 b | 0.0 ± 0.0 b |
| 0.5 | 0.0 ± 0.0 b | 0.0 ± 0.0 b |
| 1 | 0.0 ± 0.0 b | 0.0 ± 0.0 b |
Table 3.
Phytotoxic effects of Thymbra capitata EO (TC3) on Solanum nigrum, Chenopodium album, Sonchus oleraceus and Setaria verticillata seed germination.
Table 3.
Phytotoxic effects of Thymbra capitata EO (TC3) on Solanum nigrum, Chenopodium album, Sonchus oleraceus and Setaria verticillata seed germination.
| Seed Germination (%) |
|---|
| Concentration µL/mL | Solanum nigrum | Chenopodium album | Sonchus oleraceus | Setaria verticillata |
|---|
| 0 (control) | 99.00 ± 1.00 a | 98.00 ± 2.00 a | 83.00 ± 4.4 a | 95.00 ± 1.60 a |
| 0.125 | 26.00 ± 11.1 b | 0.00 ± 0.00 b | 0.00 ± 0.00 b | 19.00 ± 7.50 b |
| 0.250 | 24.00 ± 19.4 bc | 0.00 ± 0.00 b | 0.00 ± 0.00 b | 13.00 ± 6.00 b |
| 0.5 | 0.00 ± 0.00 c | 0.00 ± 0.00 b | 0.00 ± 0.00 b | 0.00 ± 0.00 c |
| 1 | 0.00 ± 0.00 c | 0.00 ± 0.00 b | 0.00 ± 0.00 b | 0.00 ± 0.00 c |
Table 4.
Phytotoxic effects of Thymbra capitata EO (TC3) on Solanum nigrum, Chenopodium album, Sonchus oleraceus and Setaria verticillata seedling length.
Table 4.
Phytotoxic effects of Thymbra capitata EO (TC3) on Solanum nigrum, Chenopodium album, Sonchus oleraceus and Setaria verticillata seedling length.
| Seedling Length (mm) |
|---|
| Concentration µL/mL | Solanum nigrum | Chenopodium album | Sonchus oleraceus | Setaria verticillata |
|---|
| 0 (control) | 47.07 ± 1.58 a | 24.71 ± 1.19 a | 17.23 ± 1.48 a | 65.00 ± 2.22 a |
| 0.125 | 12.40 ± 4.16 b | - | - | 19.94 ± 6.15 b |
| 0.250 | 2.46 ± 2.46 bc | - | - | 16.23 ± 4.97 b |
| 0.5 | - | - | - | - |
| 1 | - | - | - | - |
Table 5.
Phytotoxic effects of Thymbra capitata EO (TC4) on Amaranthus retroflexus, Portulaca oleracea, Avena fatua and Echinochloa crus-galli seed germination.
Table 5.
Phytotoxic effects of Thymbra capitata EO (TC4) on Amaranthus retroflexus, Portulaca oleracea, Avena fatua and Echinochloa crus-galli seed germination.
| Seed Germination (%) |
|---|
| Concentration µL/mL | Amaranthus retroflexus | Portulaca oleracea | Avena fatua | Echinochloa crus-galli |
|---|
| 0 (control) | 87.0 ± 2.0 a | 76.0 ± 5.8 a | 64.0 ± 5.8 a | 89.0 ± 3.5 a |
| 0.125 | 62.0 ± 6.8 b | 26.0 ± 4.8 b | 56.0 ± 9.3 a | - |
| 0.250 | 18.0 ± 1.2 c | 17.0 ± 4.1 bc | 14.0 ± 7.9 b | 50.0 ± 5.6 b |
| 0.5 | 6.0 ± 2.9 d | 9.0 ± 2.9 c | 0.0 ± 0.0 c | 31.0 ± 6.7 c |
| 1 | 0.0 ± 0.0 e | 2.0 ± 1.2 d | 0.0 ± 0.0 c | 13.0 ± 4.0 d |
| 2 | - | 0.0 ± 0.0 d | - | 0.0 ± 0.0 e |
Table 6.
Phytotoxic effects of T. capitata EO (TC4) on Amaranthus retroflexus, Portulaca oleracea, Avena fatua and Echinochloa crus-galli coleoptile and radical length.
Table 6.
Phytotoxic effects of T. capitata EO (TC4) on Amaranthus retroflexus, Portulaca oleracea, Avena fatua and Echinochloa crus-galli coleoptile and radical length.
| Coleoptile and Radicle Length (mm) |
|---|
| Concentration µL/mL | A. fatua Coleoptile Length | A. fatua Radicle Length | E. crus-galli Coleoptile Length | E. crus-galli Radicle Length |
|---|
| 0 (control) | 22.52 ± 0.78 a | 21.12 ± 1.23 a | 51.28 ± 1.88 a | 38.81 ± 1.12 a |
| 0.125 | 6.84 ± 1.43 b | 1.55 ± 0.37 b | - | - |
| 0.250 | 1.11 ± 0.48 c | 0.39 ± 0.11 b | 26.03 ± 1.59 b | 18.00 ± 2.28 b |
| 0.5 | - | - | 22.56 ± 1.84 b | 14.60 ± 1.66 b |
| 1 | - | - | 15.50 ± 0.65 c | 12.70 ± 0.60 b |
| 2 | - | - | - | - |
Table 7.
TC4 efficacy per species and per treatment. T4, T8, T12: 4, 8, 12 µL/mL EO; Cw: water control; Cf: Fitoil control.
Table 7.
TC4 efficacy per species and per treatment. T4, T8, T12: 4, 8, 12 µL/mL EO; Cw: water control; Cf: Fitoil control.
| Species | Efficacy |
| Portulaca oleracea | 60.00 ± 4.06 a |
| Avena fatua | 32.00 ± 4.06 b |
| Echinochloa crus-galli | 00.00 ± 4.06 c |
| Treatments | Efficacy |
| Cw | 0.00 ± 5.24 c |
| Cf | 0.00 ± 5.24 c |
| T4 | 33.33 ± 5.24 b |
| T8 | 53.33 ± 5.24 a |
| T12 | 66.66 ± 5.24 a |
Table 8.
Efficacy, effects on several plant traits (aerial part, root and total length, fresh and dry weight), and damage level of TC4 EO at different application doses on P. oleracea. T4, T8, T12: 4, 8, 12 µL/mL EO; Cw: water control; Cf: Fitoil control.
Table 8.
Efficacy, effects on several plant traits (aerial part, root and total length, fresh and dry weight), and damage level of TC4 EO at different application doses on P. oleracea. T4, T8, T12: 4, 8, 12 µL/mL EO; Cw: water control; Cf: Fitoil control.
| Treatments | Efficacy | Aerial Part Length (cm) | Root Length (cm) | Total Length (cm) | Fresh Weight (g) | Dry Weight (g) | Damage Level |
|---|
| Cw | 0.00 b | 6.55 b | 13.09 a | 19.64 b | 1.23 a | 0.15 a | 0.00 b |
| Cf | 0.00 b | 7.39 a | 13.87 a | 21.26 a | 1.30 a | 0.17 a | 0.00 b |
| T4 | 100.00 a | 0.00 c | 0.00 b | 0.00 c | 0.00 b | 0.00 b | 3.00 a |
| T8 | 100.00 a | 0.00 c | 0.00 b | 0.00 c | 0.00 b | 0.00 b | 3.00 a |
| T12 | 100.00 a | 0.00 c | 0.00 b | 0.00 c | 0.00 b | 0.00 b | 3.00 a |
Table 9.
Efficacy, effects on several plant traits (aerial part, root and total length, fresh and dry weight), and damage level of TC4 EO at different application doses on A. fatua. T4, T8, T12: 4, 8, 12 µL/mL EO; Cw: water control; Cf: Fitoil control.
Table 9.
Efficacy, effects on several plant traits (aerial part, root and total length, fresh and dry weight), and damage level of TC4 EO at different application doses on A. fatua. T4, T8, T12: 4, 8, 12 µL/mL EO; Cw: water control; Cf: Fitoil control.
| Treatments | Efficacy | Aerial Part Length (cm) | Root Length (cm) | Total Length (cm) | Fresh Weight (g) | Dry Weight (g) | Damage Level |
|---|
| Cw | 0.00 c | 20.16 a | 14.57 ab | 34.74 a | 0.58 a | 0.07 a | 0.20 c |
| Cf | 0.00 c | 21.74 a | 16.02 a | 37.76 a | 0.76 a | 0.07 a | 0.30 c |
| T4 | 0.00 c | 14.77 b | 11.16 b | 25.93 b | 0.44 ab | 0.05 a | 1.80 b |
| T8 | 60.00 b | 3.53 c | 3.99 c | 7.35 c | 0.09 bc | 0.02 b | 3.50 a |
| T12 | 100.00 a | 0.00 c | 0.00 d | 0.00 d | 0.00 c | 0.00 b | 4.00 a |
Table 10.
Efficacy, effects on several plant traits (aerial part, root and total length, fresh and dry weight), and damage level of TC4 EO at different application doses on E. crus-galli. T4, T8, T12: 4, 8, 12 µL/mL EO; Cw: water control; Cf: Fitoil control.
Table 10.
Efficacy, effects on several plant traits (aerial part, root and total length, fresh and dry weight), and damage level of TC4 EO at different application doses on E. crus-galli. T4, T8, T12: 4, 8, 12 µL/mL EO; Cw: water control; Cf: Fitoil control.
| Treatments | Efficacy | Aerial Part Length (cm) | Root Length (cm) | Total Length (cm) | Fresh Weight (g) | Dry Weight (g) | Damage Level |
|---|
| Cw | 0.00 | 27.19 a | 20.17 a | 47.37 a | 1.43 a | 0.15 a | 0.00 d |
| Cf | 0.00 | 26.80 a | 20.07 a | 46.88 a | 1.42 a | 0.15 ab | 0.10 d |
| T4 | 0.00 | 25.15 ab | 19.97 a | 45.12 a | 1.12 a | 0.12 abc | 0.60 c |
| T8 | 0.00 | 23.46 b | 18.14 a | 42.60 a | 1.08 a | 0.12 bc | 1.00 b |
| T12 | 0.00 | 18.39 c | 14.39 b | 32.78 b | 0.95 b | 0.10 c | 1.90 a |
Table 11.
Efficacy of TC4 on target weed species A. fatua, E. crus-galli, E. bonariensis and P. oleracea applied by irrigation or spraying. (CW—water control, CF—Fitoil control, TC4—TC4 at 4 µL/mL, TC8—TC4 at 8 µL/mL and TC12—TC4 at 12 µL/mL).
Table 11.
Efficacy of TC4 on target weed species A. fatua, E. crus-galli, E. bonariensis and P. oleracea applied by irrigation or spraying. (CW—water control, CF—Fitoil control, TC4—TC4 at 4 µL/mL, TC8—TC4 at 8 µL/mL and TC12—TC4 at 12 µL/mL).
| Avena fatua |
| Treatment | Irrigation | Spraying |
| CW | 0.00 ± 0.00 c | 0.00 ± 0.00 c |
| CF | 0.00 ± 0.00 c | 0.00 ± 0.00 c |
| TC4 | 80.00 ± 13.33 b | 0.00 ± 0.00 c |
| TC8 | 90.00 ± 9.99 ab | 60.00 ± 7.83 b |
| TC12 | 100.00 ± 0.00 a | 100.00 ± 0.00 a |
| Echinochloa crus-galli |
| Treatment | Irrigation | Spraying |
| CW | 0.00 ± 0.00 c | 0.00 ± 0.00 |
| CF | 0.00 ± 0.00 c | 0.00 ± 0.00 |
| TC4 | 10.00 ± 9.99 c | 0.00 ± 0.00 |
| TC8 | 50.00 ± 16.66 b | 0.00 ± 0.00 |
| TC12 | 100.00 ± 0.00 a | 0.00 ± 0.00 |
| Portulaca oleracea |
| Treatment | Irrigation | Spraying |
| CW | 0.00 ± 0.00 c | 0.00 ± 0.00 b |
| CF | 0.00 ± 0.00 c | 0.00 ± 0.00 b |
| TC4 | 0.00 ± 0.00 c | 100.00 ± 0.00 a |
| TC8 | 40.00 ± 16.32 b | 100.00 ± 0.00 a |
| TC12 | 90.00 ± 9.99 a | 100.00 ± 0.00 a |
| Erigeron bonariensis |
| Treatment | Irrigation | Spraying |
| CW | 0.00 ± 0.00 b | 0.00 ± 0.00 c |
| CF | 0.00 ± 0.00 b | 0.00 ± 0.00 c |
| TC2 | 10.00 ± 10.00 b | 100.00 ± 0.00 a |
| TC4 | 70.00 ± 15.30 a | 80.00 ± 13.30 b |
| TC8 | 90.00 ± 10.00 a | 100.00 ± 0.00 a |
Table 12.
Efficacy, effects on several plant traits (aerial part, root and total length, fresh and dry weight), and damage level of TC4 EO (TC) and carvacrol (CV), applied at 4 and 8 µL/mL, by irrigation (CVR4, CVR8; TCR4, TCR8) and spraying (CVP4, CVP8; TCP4, TCP8) on Avena fatua (WCR: irrigated water control; WCP: sprayed water control).
Table 12.
Efficacy, effects on several plant traits (aerial part, root and total length, fresh and dry weight), and damage level of TC4 EO (TC) and carvacrol (CV), applied at 4 and 8 µL/mL, by irrigation (CVR4, CVR8; TCR4, TCR8) and spraying (CVP4, CVP8; TCP4, TCP8) on Avena fatua (WCR: irrigated water control; WCP: sprayed water control).
| Treatments Applied by Irrigation |
| Treatment | Efficacy | Aerial Part Length (cm) | Root Length (cm) | Fresh Weight (g) | Dry Weight (g) | Damage Level |
| WCR | 0.00 c | 16.42 a | 16.10 a | 0.60 a | 0.15 a | 1.00 c |
| CVR4 | 80.00 a | 1.94 c | 0.89 c | 0.00 bc | 0.00 bc | 2.40 ab |
| CVR8 | 90.00 a | 0.99 c | 1.13 c | 0.02 bc | 0.00 c | 2.70 ab |
| TCR4 | 30.00 b | 7.63 b | 4.87 b | 0.09 b | 0.03 b | 2.00 b |
| TCR8 | 100.00 a | 0.00 c | 0.00 c | 0.00 c | 0.00 c | 3.00 a |
| Treatments Applied by Spraying |
| Treatment | Efficacy | Aerial Part Length (cm) | Root Length (cm) | Fresh Weight (g) | Dry Weight (g) | Damage Level |
| WCP | 0.00 b | 17.56 a | 16.07 a | 0.21 a | 0.10 ab | 1.00 bc |
| CVP4 | 10.00 b | 14.76 ab | 8.08 b | 0.17 a | 0.13 a | 0.30 c |
| CVP8 | 20.00 ab | 12.20 ab | 8.50 b | 0.20 a | 0.10 ab | 1.40 b |
| TCP4 | 30.00 ab | 9.45 bc | 6.27 b | 0.18 a | 0.05 ab | 1.50 b |
| TCP8 | 50.00 a | 5.03 c | 4.98 b | 0.04 b | 0.02 b | 2.60 a |
Table 13.
Temperature and relative humidity conditions (Mean, Maximum (Max.) and Minimum (Min.)) in the greenhouse during the experiments.
Table 13.
Temperature and relative humidity conditions (Mean, Maximum (Max.) and Minimum (Min.)) in the greenhouse during the experiments.
| Trial | Starting-End Date | Temperature (°C) | Relative Humidity (%) |
|---|
| Mean | Max. | Min. | Mean | Max. | Min. |
|---|
| TC3 injected into the soil/TC3+Tween20/TC3+ Fitoil | 27/02/2013–10/04/2013 | 22.3 | 34.9 | 15.8 | 49.4 | 92.8 | 14.4 |
| TC4 in pre- and post-emergence applied to weeds from soil seedbank | 27/7/2015–27/8/2015 | 29.1 | 33.9 | 18.7 | - | - | - |
| TC4 and carvacrol (4, 8 μL/mL) irrigation, spray on A. fatua | 01/05/2017–24/05/2017 | 26.1 | 35.2 | 20.1 | 66.9 | 85.6 | 45.8 |
| TC4 (4,8,12 μL/mL) spray on P. oleracea | 10/08/2018–30/08/2018 | 25.4 | 36.3 | 18.6 | 59.3 | 81.1 | 29.8 |
| TC4 (4,8,12 μL/mL) spray on A. fatua | 02/05/2018–31/05/2018 | 24.8 | 35.4 | 19.1 | 51.7 | 82.1 | 21.6 |
| TC4 (4,8,12 μL/mL) spray on E. crus galli | 26/09/2018–05/10/2018 | 24.1 | 36.3 | 18.8 | 56.0 | 88.5 | 25.5 |